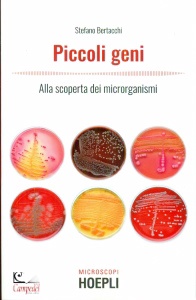
Ingrandisci immagine

Professionisti al Vostro servizio

Libreria Editrice
Campedel
Campedel
BERTACCHI STEFANO
Piccoli geni Alla scoperta dei microrganismi

Autore:
BERTACCHI STEFANO
Titolo:
Piccoli geni Alla scoperta dei microrganismi
Descrizione:
Microcosmo Microclima Microchip Micronazione Mircrocredito
Editore:
Hoepli
Data di edizione:
febbraio 2021
Pagine:
148
Dimensioni cm.:
12,5x19,5
ISBN13:
9788820399962
Codice:
332383
Collana:
Microscopi 0
Prezzo:
Disponibilità:
* Offerta valida 30 giorni (fino ad esaurimento scorte)
14.00. Nostra offerta con sconto 5%: 13.30 *
normalmente disponibile per la spedizione in 5 giorni lavorativi
Dati aggiornati a febbraio 2021
0 - 24 0
Lingua
Italiano
Allegati:
?
Modalità, tempi e costi di consegna
| Descrizione | |
|
Piccoli geni. Alla scoperta dei microrganismi Stefano Bertacchi pubblicato da Hoepli Collana Microscopi Un fantastico viaggio nel microcosmo, in cui le cellule sono capaci di farsi la guerra, ma allo stesso tempo di collaborare anche con esseri viventi ben più grandi, come l'uomo. Dal fondo dell'oceano all'interno della bocca, tanti sono i luoghi abitati da esseri viventi invisibili ai nostri occhi e fondamentali per la vita sulla Terra: i microrganismi sono assoluti protagonisti d el mondo che ci circonda, avendo colonizzato i posti più impensabili, dall'Antartide alle nuvole. Questo libro affronta la straordinaria biodiversità microbica presentando batteri, lieviti, muffe i cui nomi scientifici, a volte bizzarri e impronunciabili, nascondono incredibili caratteristiche. Dall'inferno dantesco alla macchina del caffè, questi piccoli geni stupiranno per le qualità che gli scienziati hanno osservato a lungo e applicato ai più disparati scopi, dai detersivi alle plastiche del domani. Indice Microcosmo Microclima Microchip Micronazione Mircrocredito Libreria Campedèl Belluno | |
| Scheda creata Mercoledi' 10 febbraio 2021 | |
| La collana Microscopi | |
| SCienza tecnologia società |
Guarda anche I libri dell'editore Hoepli Gli scaffali di Scienze I libri di Scienza e tecnica storia della |
© Libreria Campedèl - Piazza dei Martiri,27/d - 32100 Belluno telefono +39.0437.943153 fax +39.0437.956904 e-mail info@campedel.it |